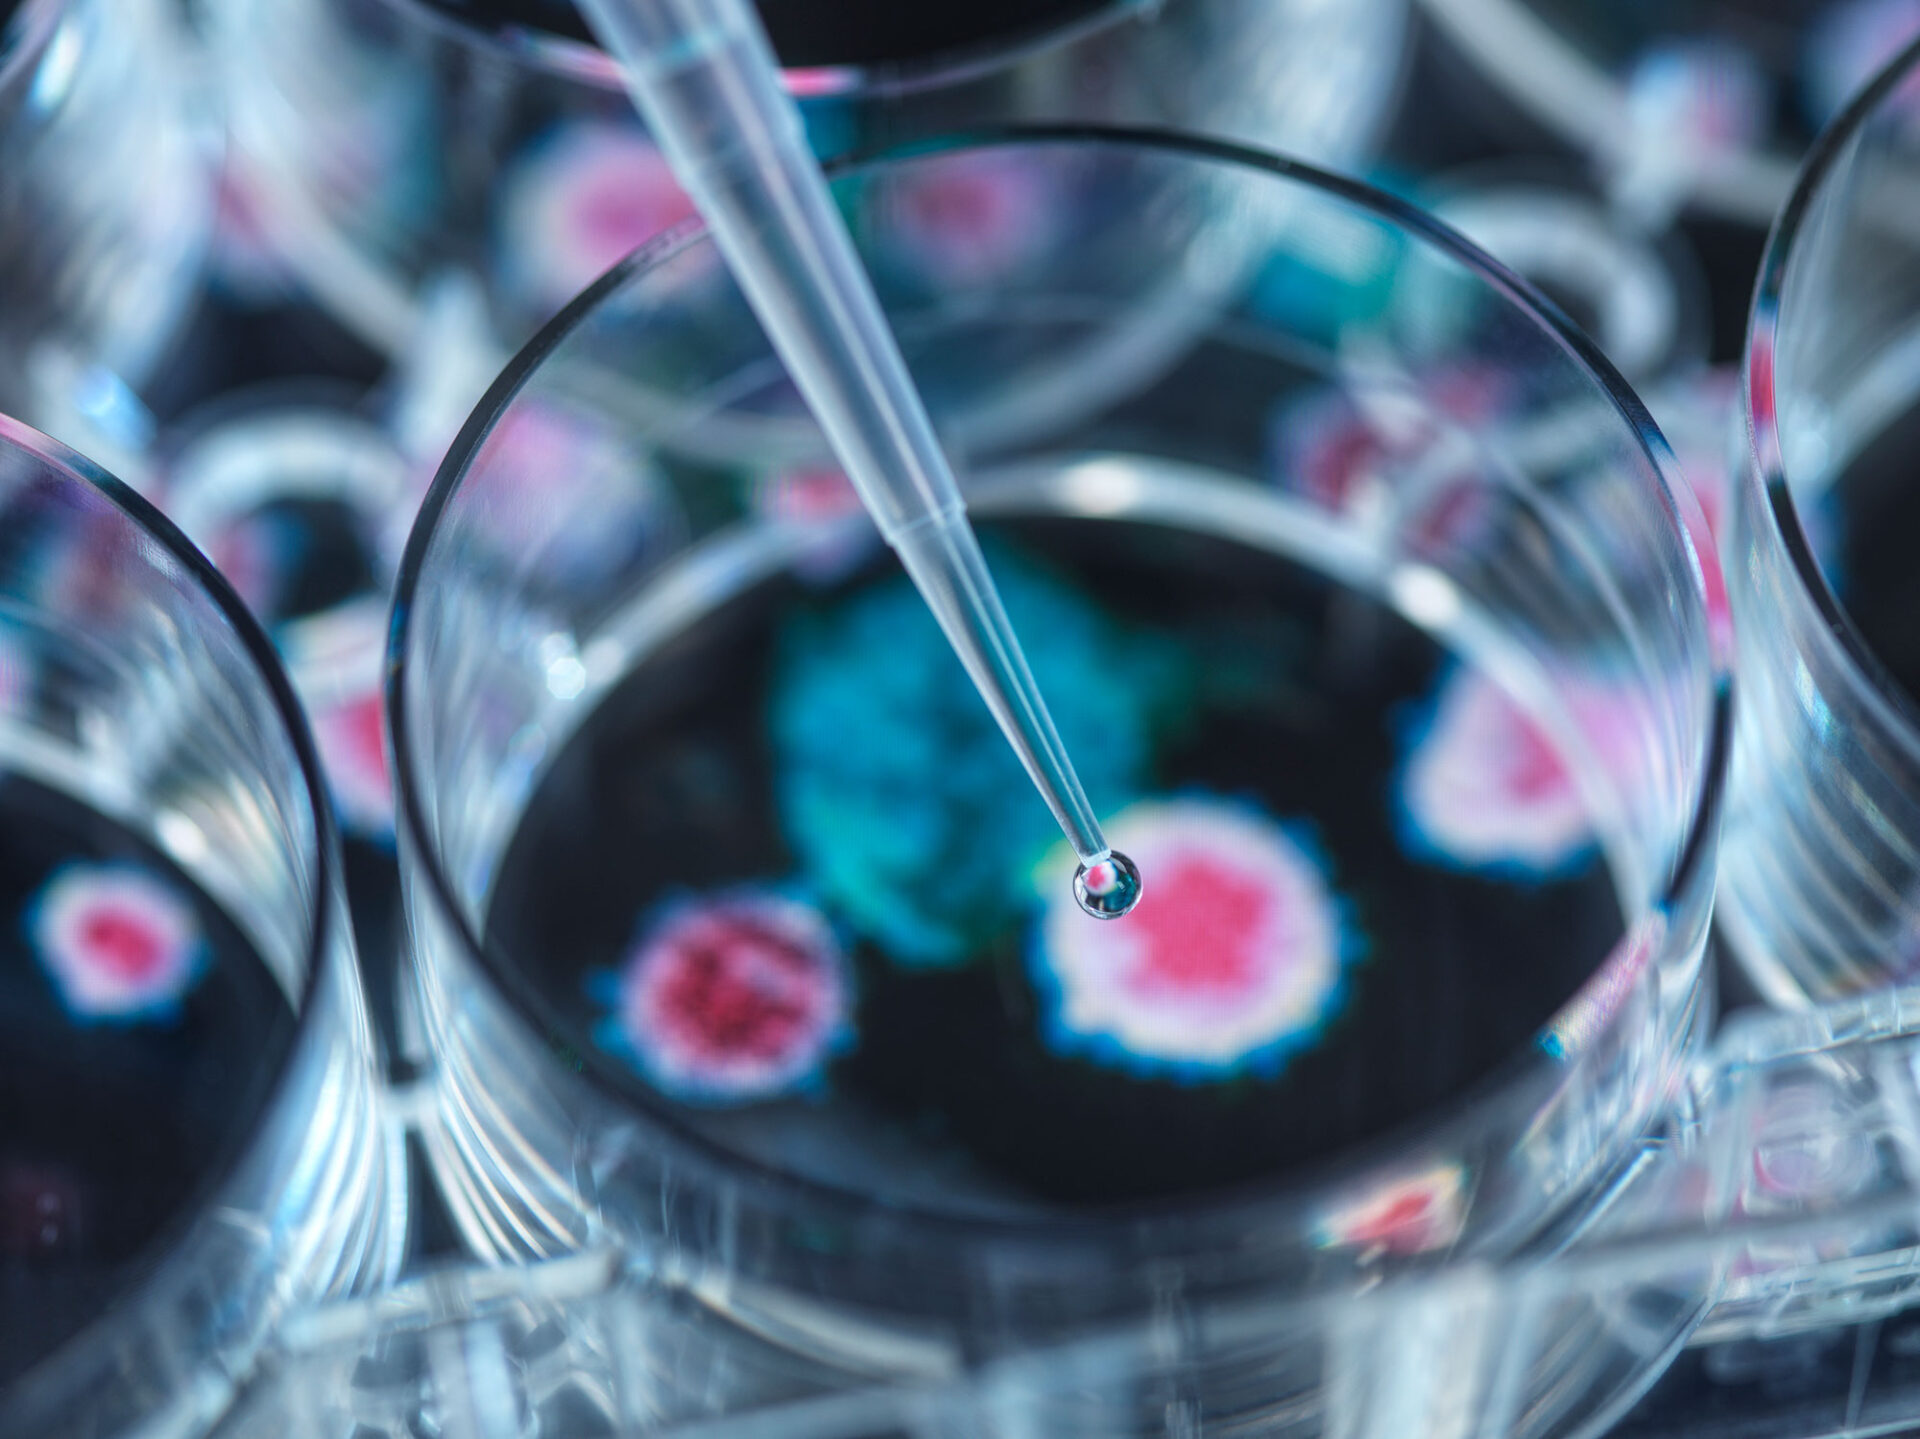

Le 17 octobre 2022, le Daily Mail a rapporté que des « chercheurs » de l’université de Boston avaient créé la « variante la plus infectieuse jamais vue » en insérant la protéine spike d’Omicron dans la souche originale Wuhan Covid. La souche Covid nouvellement créée et plus mortelle a tué 80 % des souris qui ont été exposées au virus pendant son développement. Le Daily Mail a rapporté ce qui suit :
« Des chercheurs américains ont mis au point une nouvelle souche mortelle du virus Covid en laboratoire – faisant écho au type d’expériences dont beaucoup craignent qu’elles aient déclenché la pandémie. La variante mutante – qui est un hybride d’Omicron et du virus original de Wuhan – a tué 80 % des souris infectées à l’Université de Boston… Les scientifiques ont également infecté des cellules humaines avec la variante hybride et ont constaté qu’elle était cinq fois plus infectieuse qu’Omicron. Cela suggère que le virus créé par l’homme pourrait être la forme la plus contagieuse à ce jour. » [1]
On appelle cela de la recherche, mais ce n’est pas de la recherche. C’est le mal absolu. Il n’y a aucune raison de créer un virus susceptible d’anéantir 80 % de la population mondiale si cette nouvelle souche de Covid « s’échappe » du laboratoire. Bien qu’ils prétendent étudier les virus, ces biolabs développent des agents hautement contagieux qui deviennent indirectement ou directement des armes biologiques.
Les théories du complot sont devenues réalité. Cette nouvelle souche Covid, plus mortelle, a été développée en laboratoire. Ils ne tentent plus de dissimuler ces faits. Selon le Daily Mail, il y a actuellement 63 laboratoires biochimiques dans le monde qui expérimentent des virus dangereux. Nous devrions nous inquiéter du fait que ces expériences puissent augmenter le risque de futures pandémies, d’autant plus que beaucoup pensent que la pandémie de Covid-19 de 2020 a été causée par les humains.
De nombreux pays mènent ces expériences afin de créer des souches plus mortelles et plus puissantes, et l’université de Boston vient de créer la mère de tous les virus Covid, qui a le potentiel d’anéantir 80 % des personnes infectées. A quoi pensent-ils ? Pourquoi font-ils cela ? À moins, bien sûr, qu’ils ne veuillent que nous fassions confiance aux scientifiques qui nous disent qu’ils ont tout sous contrôle et que tout va bien se passer. Qu’est-ce qui pourrait bien se passer quand la nature humaine déchue et pécheresse est chargée de protéger ces armes biologiques mortelles ?
Alors que les politiciens et les activistes climatiques nous avertissent que nous devons modifier considérablement notre mode de vie afin d’échapper à une calamité climatique catastrophique qui détruirait la Terre, des laboratoires biochimiques mettent au point des virus super mortels qui pourraient tuer des millions de personnes. C’est complètement insensé. N’avons-nous rien appris ? Nous venons de passer par deux années de confinement, de mandats de masques, de mandats de vaccination, de destruction de petites entreprises, de perte d’emploi et de perte de liberté civile et religieuse pendant la pandémie de Covid-19. Combien de fois encore voulons-nous répéter cela ?
Pourquoi permettons-nous à ces laboratoires de modifier les virus pour les rendre plus mortels ? Pourquoi cela se produit-il ? Il n’y a aucune raison de faire cela, à moins que des entreprises pharmaceutiques telles que Pfizer, Moderna, AstraZeneca, Johnson & Johnson et d’autres ne financent ces projets afin de nous vendre davantage de vaccins et de dose de rappels. Peut-être le gouvernement finance-t-il ces expériences biochimiques en vue des prochaines élections, des futurs confinements et de la fin de nos libertés constitutionnelles telles que nous les connaissons. Ou peut-être que les mondialistes ont besoin de plus de chaos dans notre monde afin de faire avancer la Grande Réinitialisation.
Une chose est sûre : tôt ou tard, nous apprendrons qu’une nouvelle souche super létale de Covid est arrivée « accidentellement ». Mais nous n’aurons pas à nous inquiéter car un nouveau médicament aura déjà été mis au point. De nouveaux vaccins seront créés avec leurs interminables rappels. De nouveaux masques obligatoires, de nouvelles fermetures, de nouveaux identifiants numériques, une nouvelle monnaie numérique et un nouveau système économique mondial verront également le jour. Et pour sauver la planète de ce virus « accidentel », un Nouvel Ordre Mondial basé sur le totalitarisme émergera.
L’inspiration nous dit que certaines maladies sont créées pour apporter la ruine et la désolation :
« Pour compléter sa moisson d’âmes non préparées à mourir, le tentateur se sert aussi des éléments. Il a étudié les secrets des laboratoires de la nature et, dans la mesure où Dieu le lui permet, il use de tout son pouvoir pour diriger les éléments. […] En outre, tout en se faisant passer pour un grand médecin capable de guérir toutes les affections, il répandra sur des villes populeuses la maladie et les calamités. » (La Tragédie des Siècles, p.638-639)
[1] https://www.dailymail.co.uk/health/article-11323677/Outrage-Boston-University-CREATES-Covid-strain-80-kill-rate.html